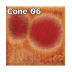
Mayco Jungle Gems™ Glaze – Dragon's Breath (4 oz)

Mayco Jungle Gems™ Glaze – Dragon's Breath (4 oz)
$23.95USD
Out Of Stock
- Brand: Mayco Colors
- Model #: MAYCO-CG972
Most products ship within 1 business day. Learn More
Mayco Jungle Gems™ Glaze – Dragon's Breath (4 oz)
Cone 06 oxidation: Masquerade is an opaque black base glaze that has red, orange, yellow, and green crystals that melt/bloom.
Cone 6 oxidation: Base glaze remains – crystals fade and melt. Enhanced mobility. Surface issues may occur.
Jungle Gems™ Crystal Glazes transform in the kiln when the small pieces of glass frit burst into color and intricate patterns during the firing process. Artists use these beautiful glazes to add dramatic, colorful effects to their creations.
Chips shown are fired flat on a white clay body fired to cone 06 oxidation and cone 6 oxidation. The choice of clay body, the thickness of glaze application, the firing process, and temperature will affect the fired results.
NOT Food & Dinnerware Safe